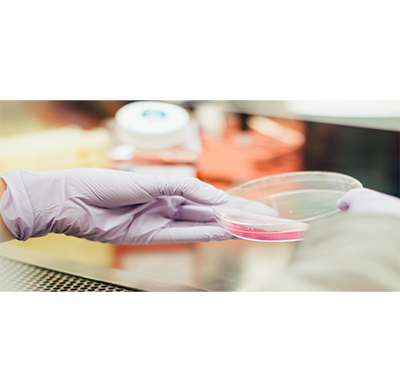

SECRET INGREDIENT OF MAYANS-TEPEZCOHUITE

All of LaVigne Natural Skincare’s products feature Tepezcohuite (pronounced ‘tep-ez-co-heety’). Derived from the bark of Mexico’s ‘skin tree’, this non-toxic wild-harvested ingredient was used by the Mayans for more than ten centuries to nourish skin.
World-renowned spas, such as Las Ventanas al Paraiso in Los Cabos, use Tepezcohuite in some of their exclusive spa treatments (available to their clientele on a very limited basis). LaVigne Natural Skincare now makes this special botanical gift from Mother Earth available to you.
Research

In 1984, a group of medics witnessed a phenomenon in Mexico City. Hundreds of people had been severely burned in a series of explosions in a gas factory. The Red Cross successfully treated victims by dusting their wounds with Tepezcohuite powder.
Tepezcohuite’s regenerative action on the injured tissues worked wonders: it was so effective that it was used one year later when an earthquake caused a gas explosion in the Aztec capital.
For many years, principal health institutions in Mexico have studied Tepezcohuite, also known as the ‘skin tree’.

SYNERGY BETWEEN 21st CENTURY SCIENCE AND TEPEZCOHUITE

Located in Vancouver, British Columbia, our cosmetics lab specializes in testing and producing natural skincare products designed to help your skin feel healthier and rejuvenated. Our staff of chemists has over 20 years of experience in product formulation, research and development. The facility is equipped with automated state-of-the-art machinery that is operated by highly skilled staff to maintain quality control. We follow strict Health Canada guidelines and GMP procedures in the formulation and manufacturing of all our products.
INGREDIENTS

- Acacia Senegal Gum
- Allantoin
- Aloe Barbadensis Leaf Gel*
- Anthemis Nobilis Flower Extract*
- Arctium Lappa (Burdock Root) Powder
- Argania Spinosa Kernel (Argan) OilArginine
- Arnica Montana (Arnica) Flower Extract*
- Artemisia Umbelliformis Extract
- Arthemis Nobilis (Chamomile) Oil
- Ascophyllum Nodosum (Kelp) Powder
- Ascorbic Acid Polypeptide*
- Avena Sativa (Oat) Flour
- Bentonite Clay
- Betula Alba (Birch) Bark Extract
- Boswellia Serrata Extract
- Brown Sucrose (Brown Sugar)
- Bulbine Frutescens Leaf Juice
- Butyrospermum Parkii (Shea Butter)
- Caffeine
- Calendula Officinalis Flower Extract*
- Camellia Sinensis (Green Tea) Leaf Extract*
- Cananga Odorata (Ylang Ylang) Flower Oil
- Capsicum
- Carica Papaya Fruit Extract
- Carica Papaya Fruit Extract
- Cellactive®Shape (Aqua (and) Alcohol Denatured (and) Caffeine (and) Coleus Forskohlii Root Extract (and) Chlorella
Vulgaris/Lupinus Albus Protein Ferment) - Cellulose Gum
- Chamomilla Recutita (Matricaria) Flower Extract*
- Chlorella Vulgaris/Lupinus Albus Protein Ferment
- Chondrus Crispus (Irish Moss) Powder
- Citrus Auranitum Bergamia Fruit Extract
- Citrus Aurantium (Neroli) Oil
- Citrus Aurantium Amara Flower Extract
- Citrus Grandis (Grapefruit) Seed Extract
- Citrus Paradisi (Grapefruit) Fruit Extract*
- Coleus Forskohlii Root Extract
- Cupressus Sempervirens (Cypress) Leaf Oil
- Cupressus Sempervirens Leaf/Stem Extract
- Dimethylaminoethanol (DMAE)
- Dioscorea Villosa (Wild Yam) Root Extract*
- Emulsifying (Vegetable) Wax [Arachidyl Alcohol (and) Behenyl Alcohol (and) Arachidyl Glucoside]
- Epilobium Angustifolium Flower/Leaf/Stem (Canadian Willowherb) Extract
- Ethylhexylglycerin
- Eugenia Caryophyllus Flower Extract
- Euphorbia Cerifera Wax
- Euterpe Oleracea (Acai) Juice*
- Evaporated Cane Juice*
- Ferulic Acid
- Fucus Vesiculosis (Seaweed) Extract*
- Gamma Aminobutyric Acid (GABA)
- Ganoderma Lucidum (Mushroom) Extract
- Gardenia Jasminoides Meristem Cell Culture
- Ginkgo Biloba Leaf Extract*
- Ginkgo Biloba Leaf Powder
- Glycerin*
- Glycine Soja (Soybean) Extract*
- Glycyrrhiza Glabra (Licorice) Root Extract*
- Hamamelis Virginiana (Witch Hazel)*
- Helianthus Annuus (Sunflower) Seed Oil*
- Himalayan Crystal Salt Crystals
- Hyaluronic Acid
- Hydrogenated Olive Oil Stearyl Esters
- Hydrolyzed Fish Collagen (Naticol) 300mg
- Hydrolyzed Keratin
- Hydrolyzed Rice Protein (and) Lactobacillus Ferment
- Illicium Verum (Star Anise) Extract
- Iron Oxide
- Jasminum Officinale Flower/Leaf Extract
- Kaolin Clay
- Lavandula Angustifolia (Lavender) Essential Oil
- Lavandula Angustifolia (Lavender) Flower Extract*
- Macrocystis Pyrifera (Sea Kelp) Extract
- Maltodextrin
- Mangifera Indica (Mango) Butter*
- Medicago Sativa (Alfalfa) Flower*
- Mica
- Mimosa Tenuiflora (Tepezcohuite) Bark Extract
- Montmorillonite (Green French Clay)
- Olea Europea (Olive) Oil
- Organical Dew Drops (Vegetable Glycerin (and) Aqua (and) Zizyphus Jujuba (Jujube) Fruit Extract (and) Macrocystis Pyrifera (Sea Kelp) Extract (and) Yeast Extract (and) Chondrus Crispus (Carrageenan/Irish Moss) Extract (and) Porphyra Umbilicalis (Nori) Extract (and) Gluconolactone (and) Sodium Benzoate)
- Oryza Sativa (Rice) Powder (Flour)
- Palmitoyl Tripeptide-5
- Panax Ginseng Root Extract*
- Panthenol
- Pectin
- Persea Gratissima (Avocado) Oil
- Phaseolus Angularis (Adzuki) Powder
- Plukenetia Volubilis Seed Oil*
- Potassium Sorbate
- Prunus Amygdalus Dulcis (Sweet Almond) Oil
- Pyrus Malus Fruit Extact
- Retinyl Palmitate (Vitamin A)
- Rosa Canina Fruit Oil
- Rosamarinus Officinalis Leaf Extract
- Rosmarinus Officinalis (Rosemary) Leaf Extract*
- Rosmarinus Officinalis (Rosemary) oil
- Rubus Idaeus (Raspberry)Seed Powder
- Rubus Idaeus Fruit Extract
- Saccharomyces (and) Copper Ferment
- Salix Alba (White WillowBark) Powder
- Salvia Officinalis Leaf Extract
- Salvia Sclarea (Clary Sage) Oil
- Simmondsia Chinensis (Jojoba) Seed Oil
- Sodium Ascorbyl Phosphate
- Sorbic Acid
- Sorbitan Olivate
- Sorbitan Palmitate
- Soybean Glycerides
- Sunflower Oil*
- Superoxide Dismutase (SOD)
- Swertia Chirata Extract
- Tapioca Syrup*
- Taraxacum Officinale (Dandelion) Extract*
- Teprenone
- Tetrahexyldecyl Ascorbate
- Theobroma Cacao (Cocoa) Seed Butter
- Titanium Dioxide
- Tocopherol
- Ubiquinone (CoEnzyme Q10)
- Yeast Extract (Phyto-Hyaluronate)
- Zinc Oxide

